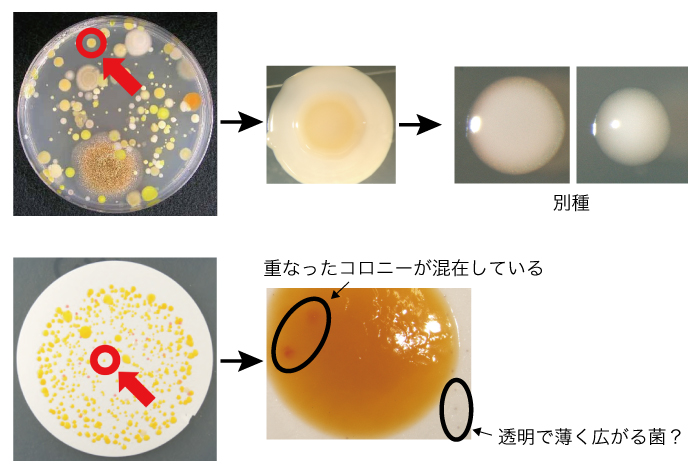
MALDI_他の試験で使用された検体

即日報告ができない検体について
当社のMALDI微生物同定試験では、細菌・酵母の純粋培養物で、当日午前中までに受入手続きが完了した検体について、原則として即日報告を行っています。
ただし、検体の状態や到着条件などにより、即日報告の対象外となる場合がございます。
サービスページでは説明しきれない内容について、以下に詳しくご説明いたします。
あらかじめご了承下さい。
1. 純粋な単一コロニーが得られていない検体、特殊な培地で培養した検体
〈対象例〉
- 液体培養物
- 混釈培養物
- ペトリフィルム
- 選択培地で培養した検体 など
このような検体を受領した場合、当社にて純化作業または再培養が必要になるので、即日報告の対象外となります。
純化作業や再培養を実施した場合、追加費用および追加納期が発生します。
▼以下の表をご参照下さい。(参考情報【同定を目的とした培養平板物について】)
| 検体の状態 | 参考イメージ | 即日報告の可否 |
|---|---|---|
| 純化済みの単一コロニーが生育した培養物 | ![]() | 可能 |
| 純化されてない複数種の単一コロニー 〈例〉菌数測定後の検体 | ![]() | ・目的コロニーに〇印の指定がある場合:可能 ・目的コロニーに〇印の指定がない場合:対象コロニーが判断できないため即日報告ができません |
| 液体培養物、混釈培養物、ペトリフィルム、選択培地で培養した検体など | | 指定培地による純化や再培養が必要のため、即日報告ができません |
2. 受入手続きが当日12:00までに完了しない検体
以下の事情により、当日12:00までに受入手続きが完了しない場合、即日報告の対象外となります。
- 区分変更が発生した場合
(例:細菌・酵母として到着した検体がカビだった、またはその逆) - 検体の到着時間が遅い場合
検体到着時間についての参考情報【検体を発送いただく際の運送会社について】
3. グルーピング作業をご希望される検体
コロニー性状による同種/別種を判断するグルーピング作業を実施する場合、追加費用および追加納期が発生するため、即日報告の対象外となります。
4. 冷蔵で保管・輸送された検体(細菌・酵母)
細菌・酵母の純粋培養物であっても、冷蔵で保管または輸送された検体は再培養が必要になるので、即日報告の対象外となります。
再培養を実施した場合、追加費用および追加納期が発生します。
5. 他の試験で使用された検体
他の試験で使用された検体は、新鮮な状態ではない可能性が高いです。
また、以下の図のように、見た目は単一であっても、重なったコロニーが混在している可能性があります。
そのため、
- お客様にて純化してからご送付いただく
- 当社で純化作業を実施
のいずれかが必要となり、純化作業を行う場合は追加費用および追加納期が発生します。

培養、保管、輸送の条件が結果に与える影響
MALDI-TOF MS法は、菌体を構成するタンパク質のマススペクトルパターンを利用して同定します。
また、MALDI Biotyperのデータベースは、新鮮な菌株から取得されたマススペクトルパターンを基に構築されています。
そのため、長期間の培養や冷蔵での保管・輸送により菌体のタンパク質構成が変化した検体では、試験結果が未同定となる可能性が高くなります。
より正確な同定結果をご提供するため、お客様には以下のことへのご協力をお願いしております。
細菌・酵母の場合
■ 培養から解析までの経過時間
- コロニー径が 1〜2 mm 程度に成長した段階で、速やかにご送付下さい。
(培養時間目安:24〜48時間) - 以下の場合は、検体を再培養し新鮮な状態の検体をご送付下さい。
① 培養開始から当社到着までに 1週間以上 経過する場合(成長が遅い菌株でコロニーが確認できるまで時間を要する場合はご相談下さい)
② 十分な大きさのコロニーが生育した後、その検体が当社に到着するまで 3日以上 経過する場合
再培養が必要かどうか判断する際、以下の表をご参照下さい。
あくまで参考となりますので、ご不明な点がございましたらお気軽にお問い合わせ下さい。

■ 保管・輸送条件
- 検体は必ず常温保管・常温輸送して下さい。
- 一度冷蔵した検体は、お客様にて再培養のうえ、常温でご送付下さい。
(当社での再培養:1,000円(税抜)〜 )
カビの場合
■ 培養から解析までの経過時間
- 解析前に当社で培養を行うため、培養後の時間経過が長くても、生育が認められる検体なら解析可能です。
- お客様にて再培養は不要です。
■ 保管・輸送条件
- 冷蔵された検体であっても、当社で培養を行うため、お客様にて再培養は不要です。
- 常温でそのままご送付下さい。

